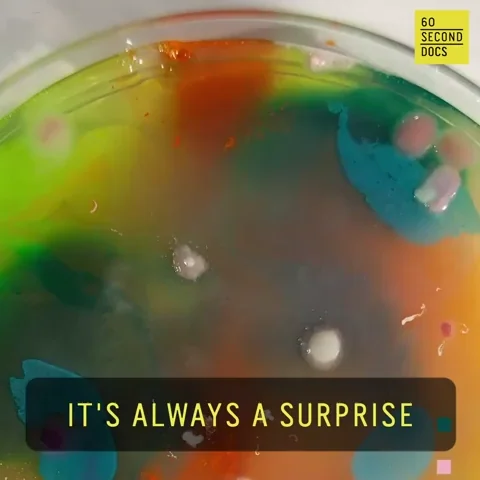
Surprise Mold GIF by 60 Second Docs

Es gibt ja Leute, die sagen, dass Red Bull nur deshalb Energy Drinks macht, um dann Sport Teams zu kaufen und irgendwelche Weltrekorde mit krassen Stunts aufzustellen.
Manchmal frage ich mich, wie es bei dir ist mit dem Growen und dem restlichen Zeug im Zelt 
2 „Gefällt mir“
#Update Tag 47:
Die Schimmelfini hatte schon wieder leichte Anzeichen von Mehltau….
Aus dem Zelt geholt. Großzügig entlaubt und den ganzen Popkorn Kram abgeschnitten….
Biobizz Leafcoat drüber gesprüht und jetzt abwarten und Minztee  trinken…
trinken…
Grüße 
13 „Gefällt mir“
Wirklich herrlich anzuschauen dein Garten!

5 „Gefällt mir“
#Update Tag 50:
Der Mehltau ist zurück. Diesmal auf einer der Gurken  …. Paar Blätter ab und Leafcoat dusche….
…. Paar Blätter ab und Leafcoat dusche….
Die Fini hatte nichts, aber auch dusche  bekommen.
bekommen.
In den Leeren Rooti nen Easy Plug mit nem ACE Seed rein gemacht…
Malawi x NL Auto 
Paar Gurken  geerntet…
geerntet…
Grüße 

16 „Gefällt mir“
#Update Tag 54/5:
Die ACE Malawi x NL Auto  hat heute das Licht
hat heute das Licht  der Welt
der Welt  erblickt.
erblickt.
Die Schimmelfini bisschen gegossen, 1 L LW
Leider kann ich die Lampe für die Malawi nicht in der Höhe anpassen. Die Gurke  hat die fest im Griff…
hat die fest im Griff…
Vielleicht hänge ich noch ne Stixx um…
Grüße 
15 „Gefällt mir“
Update vom Update:
Konnte die Gurke  in einer kurzen Diskussion überzeugen die Lampe los zu lassen…
in einer kurzen Diskussion überzeugen die Lampe los zu lassen…
Grüße 

14 „Gefällt mir“
#Update Tag 57:
Es wächst. Gurke und Tomaten geerntet.
Grüße 
14 „Gefällt mir“
Cooler Faden, gefällt mir was du da treibst. Viel Glück mit dem Mehltau.
1 „Gefällt mir“
Moin, vielen Dank 
Bis jetzt ist der Mehltau nicht wieder aufgetaucht…
Grüße

4 „Gefällt mir“
Du bist einfach unglaublich! 
Warum hab ich das alles verpasst.?
So geil  .
.
Schöner als mein Balkon.
GRÜNLIEBE 
3 „Gefällt mir“
Dankeschön 
Dein Balkon ist auch sehr schön 
Grüße 
2 „Gefällt mir“
#Update Tag 60:
Regenwürmer  sind eingezogen.
sind eingezogen.
 Gemüse gegossen.
Gemüse gegossen.
Sonst ist nichts zu tun…
Grüße 
21 „Gefällt mir“
Update Tag irgendwas, auf jeden Fall der letzte!
So, mir reicht es! Die Schimmelfini hat mich genug geärgert.
Chemische Keule wollte ich nicht einsetzen…
So viel war jetzt auch nicht dran.
Die hatte schon Mehltau als sie noch klein war…
Habe jetzt die Schere ganz unten angesetzt.
Jetzt stecke ich all meine Liebe in die Malawi  .
.
Grüße 
17 „Gefällt mir“
Update Tag 22:
Die Malawi und eine Gurke hatten wieder Mehltau.
Die Gurke wurde aus dem Zelt entfernt.
Die Malawi hat eine ordentliche EM Dusche  bekommen und sieht gerade etwas traurig aus.
bekommen und sieht gerade etwas traurig aus.
Die Oxus Auto von Don Seed ist gekeimt.
Bin am überlegen ob ich noch einen Gurken Samen in die Erde stecken…
Weiß gerade aber nicht welchen, es sind so viele Sorten da. Das ufert jetzt schon wieder aus wie bei den Ladys.
Grüße 
.
15 „Gefällt mir“
Ja, Dankeschön 
Das ist voll Mist. Ich hoffe ich bekomme das jetzt in den Griff…
5 „Gefällt mir“
Was für ein schönes Zelt hast du denn? Ein richtiger Selbstversorger Garten 
4 „Gefällt mir“
Hatte da mit meiner Freundin drüber gesprochen und ihre Frage war… „Weißt du wo der Mehltau her kam“? Also vllt welche Pflanze zuerst betroffen war!?
3 „Gefällt mir“
![]() und stark…
und stark…![]() liefern auch ordentlich, komme kaum mit dem essen hinterher…
liefern auch ordentlich, komme kaum mit dem essen hinterher…![]() auf der Pizza gestern habe ich jetzt mehrfach bereut. Angeschnitten und frisch probiert, war noch in Ordnung. Aber auf der Pizza
auf der Pizza gestern habe ich jetzt mehrfach bereut. Angeschnitten und frisch probiert, war noch in Ordnung. Aber auf der Pizza ![]()
![]()
![]()
![]()
![]()
![]()
![]()
![]()
![]() mal schauen was ich mit der pflanze
mal schauen was ich mit der pflanze ![]() mache… Könnte was für Chili con carne sein. Werde ich mal ausprobieren… sonst kommt die weg….
mache… Könnte was für Chili con carne sein. Werde ich mal ausprobieren… sonst kommt die weg….![]()